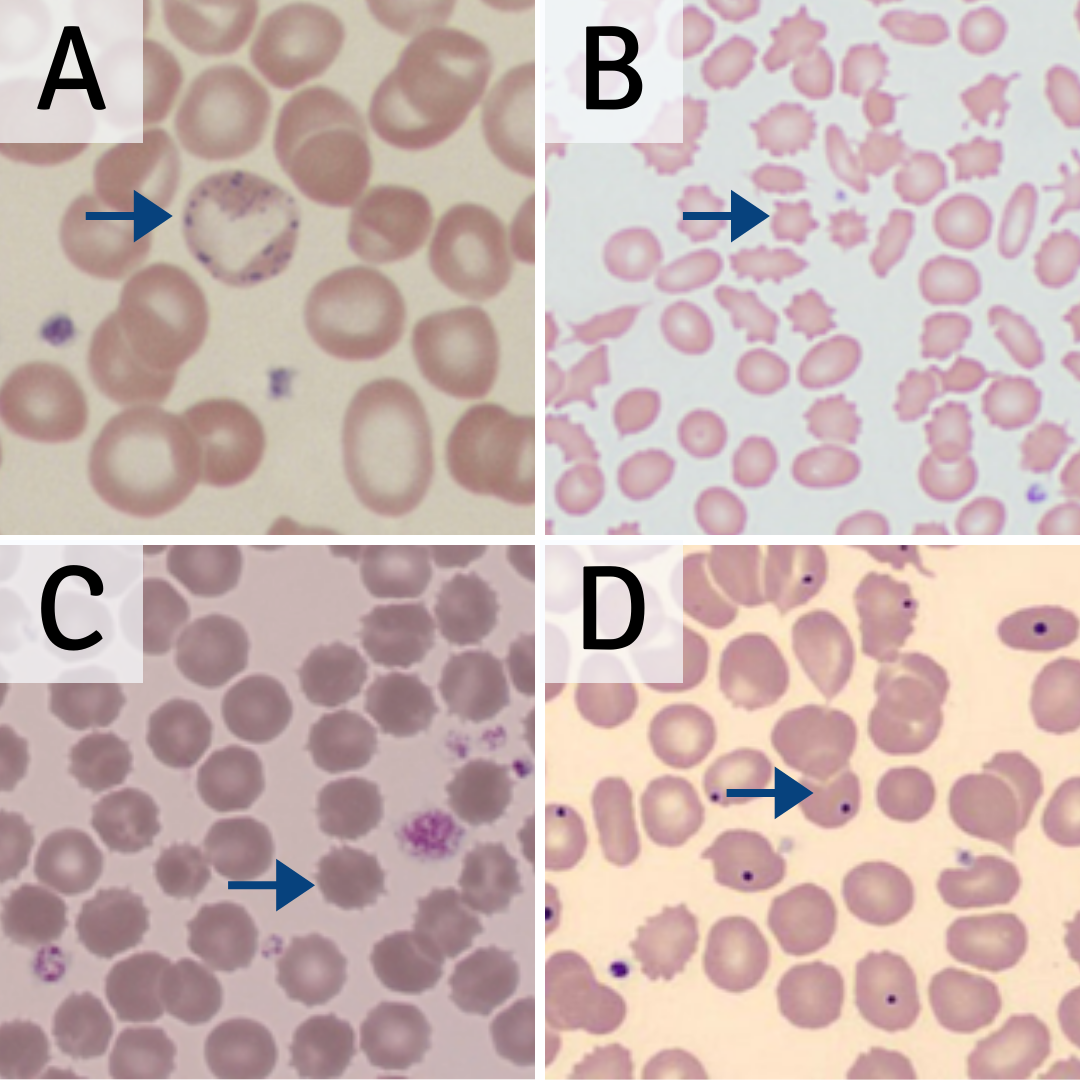

Essential Blood Cell Morphology Course
-
LessonsLesson 1 – Red cells1 Assessment
-
Course IntroductionHow the course works
Quiz Summary
0 of 13 questions completed
Questions:
Information
You have already completed the quiz before. Hence you can not start it again.
Quiz is loading…
You must sign in or sign up to start the quiz.
You must first complete the following:
Results
Results
0 of 13 Questions answered correctly
Your time:
Time has elapsed
You have reached 0 of 0 point(s), 0
Earned Point(s): 0 of 0, (0)
0 Audio(s)/Essay(s) Pending (Possible Point(s): 0)
Categories
- Not categorized 0%
- 1
- 2
- 3
- 4
- 5
- 6
- 7
- 8
- 9
- 10
- 11
- 12
- 13
- Current
- Review
- Answered
- Correct
- Incorrect
-
Question 1 of 13
1. Question
Question 1
Adult Haemoglobin is composed of what combination of globin chains? (1 point)
Please select one option
CorrectIncorrect -
Question 2 of 13
2. Question
Question 2
What is the average lifespan of a normal, mature red cell? (1 point)
Please select one option.
CorrectIncorrect -
Question 3 of 13
3. Question
Question 3
What red cell precursor is found in the blood under normal circumstances in the adult? (1 point)
Please select one option.
CorrectIncorrect -
Question 4 of 13
4. Question
Question 4
Polychromasia describes an increase in what red cell precursor in the blood? (1 point)
Please select one option.
CorrectIncorrect -
Question 5 of 13
5. Question
Question 5
Order the following red cell precursors in order of maturity, starting with the most immature. (1 point)
-
Pronormoblast
-
Basophilic normoblast
-
Polychromatic normoblast
-
Orthochromatic normoblast
-
Reticulocyte
CorrectIncorrect -
-
Question 6 of 13
6. Question
Question 6
The size of a normal, mature red cell is equivalent to the nucleus size of which of the following cells? (1 point)
Please select one option.
CorrectIncorrect -
Question 7 of 13
7. Question
Question 7
Match the following red cell inclusion with the most appropriate description. (5 points)
Drag the descriptions below to the most appropriate option in the table.
Sort elements
- DNA
- Iron
- RNA
- Denatured haemoglobin
- Microtubule
-
Howell-Jolly body
-
Pappenheimer body
-
Basophilic stippling
-
Heinz body
-
Cabot ring
CorrectIncorrect -
Question 8 of 13
8. Question
Question 8
When examining the blood film, which one of the following cells/features is least likely to be seen in cases of warm autoimmune haemolytic anaemia? (1 point)
Please select one option.
CorrectIncorrect -
Question 9 of 13
9. Question
Question 9
Match the labelled cell with the appropriate description. (4 points)


Sort elements
- Mature red cell
- Polychromatic normoblast
- Orthochromic normoblast
- Pronormoblast
-
A
-
B
-
C
-
D
CorrectIncorrect -
Question 10 of 13
10. Question
Question 10
Match the labelled cell with the appropriate description. (4 points)
Sort elements
- Basophilic stippling
- Acanthocyte
- Echinocyte
- Howell-Jolly body
- Polychromasia
- Background staining
- Sickle cell
-
A
-
B
-
C
-
D
CorrectIncorrect -
Question 11 of 13
11. Question
Question 11
Match the labelled cell with the appropriate description. (4 points)

Sort elements
- Elliptocyte
- Rouleaux
- Red cell agglutination
- Hypochromia
- Red cell rosetting
- Pencil cell
- Stomatocyte
- Teardrop cell (dacrocyte)
-
A
-
B
-
C
-
D
CorrectIncorrect -
Question 12 of 13
12. Question
Question 12
Match the labelled cell with the appropriate description. (4 points)

Sort elements
- Sickle cell
- Schistocyte (red cell fragment)
- Codocyte (target cell)
- Stomatocyte
- Spherocyte
- Oval macrocyte
- Elliptocyte
-
A
-
B
-
C
-
D
CorrectIncorrect -
Question 13 of 13
13. Question
Question 13
Match the labelled cell with the appropriate description. (4 points)

Sort elements
- Spherocyte
- Polychromasia
- Bite cell (degmacyte)
- Teardrop cell (dacrocyte)
- Nucleated red cell
- Schistocyte
- Codocyte (target cell)
- Acanthocyte
-
A
-
B
-
C
-
D
CorrectIncorrect
